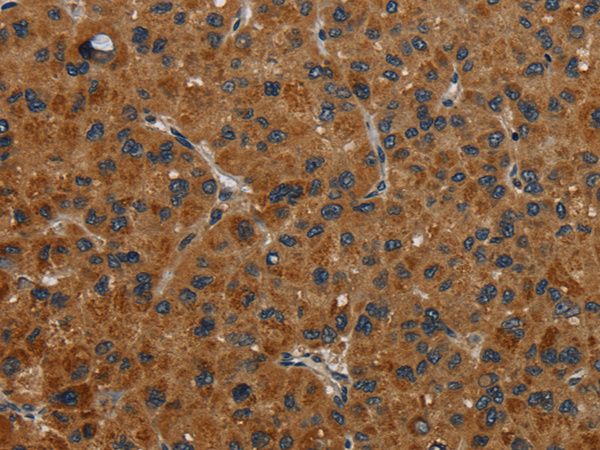

-
分类: 科研抗体货号: P08340别名: FKBP38; FKBPr38应用: WB,IHC反应种属: Human, Mouse, Rat
-
分类: 科研抗体货号: P08338别名: FLN; FMD; MNS; OPD; ABPX; CSBS; CVD1; FLN1; NHBP; OPD1; OPD2; XLVD; XMVD; FLN-A; ABP-280应用: WB,IHC反应种属: Human, Mouse
-
分类: 科研抗体货号: P08359别名: GPIP4; GCDFP15; GCDFP-15应用: IHC反应种属: Human
-
分类: 科研抗体货号: P08337别名: HEL-S-78p应用: WB,IHC反应种属: Human, Mouse, Rat
-
分类: 科研抗体货号: P08380别名: GE; GPC; GPD; GYPD; CD236; PAS-2; CD236R; PAS-2应用: IHC反应种属: Human
-
分类: 科研抗体货号: P08358别名: GBP-5应用: WB,IHC反应种属: Human
-
分类: 科研抗体货号: P08372别名: GR; GCR; GRL; GCCR; GCRST应用: WB,IHC反应种属: Human, Mouse, Rat
-
分类: 科研抗体货号: P08379别名:应用: IHC反应种属: Human, Mouse, Rat
-
分类: 科研抗体货号: P08356别名: GANP; SAC3; MAP80应用: WB,IHC反应种属: Human
-
分类: 科研抗体货号: P08371别名: GLYI; GLOD1; HEL-S-74应用: WB,IHC反应种属: Human, Mouse, Rat

鄂公网安备42018502007531号
鄂公网安备42018502007531号

